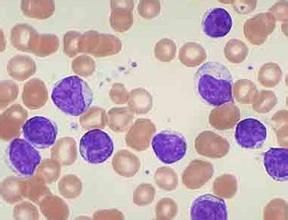
急性淋巴細胞白血病

簡介
急性淋巴細胞白血病塗片急性淋巴細胞性白血病(acutelymphoblasticleukemia,ALL)是小兒時期最常見的類型,發病高峰年齡為3~4歲,男孩發病率略高於女孩,二者的比例約為1.1~1.6∶1。
急性淋巴細胞白血病按免疫標誌分為非T細胞型和T細胞型。
前者又可分為無標誌性急淋、普通型急淋、前B細胞型急淋和B細胞型急淋4個亞型;T細胞型又分為不成熟胸腺細胞型,普通的胸腺細胞型和成熟胸腺細胞型。
骨髓移植是治癒急性淋巴細胞白血病的方法。化療緩解後首選全相合骨髓移植,無全相合供者病人,選擇半相合骨髓移植也能達到同樣的療效。
分型
急性淋巴細胞白血病分型
⒈按細胞大小(FAB我國標準)
①L原幼淋細胞以小細胞為主大細胞﹤(%)
②L原幼淋細胞以大細胞為主>(%)
③L大細胞為主胞質較多深藍色多空泡呈蜂窩狀稱BurKitt型
⒉按細胞表型(WHO標準)
①前體B--ALL:細胞形態學如L或L免疫表型為B系:CDCDCDaCD陽性TdT^+占ALL中%~~%
②前體T-ALL:細胞形態學如L或L免疫表型為T系:CDCDCDCD陽性TDT亦可陽性占ALL中%~~%
WHO將L(BurKitt型)歸入成熟B細胞腫瘤中
根據形態學、免疫學和遺傳學分型(即MIC分型),可分為幾個亞型。治療及預後與分型密切相關。
急性淋巴細胞白血病1、形態學分型目前國際通用FAB分型,即按照細胞大小、核漿比例、核仁大小及數目、胞漿嗜鹼程度,將急淋分為L1~L3三型。小兒ALL以L1型最多見,約占70%左右,L2型約為25%左右,L3型僅占0~4%。
2、免疫學分型白血病發生學的成熟遏制學說認為,白血病是造血細胞的某一克隆被阻滯在某一分化階段上並異常增殖的結果。因此白血病細胞具有相應的正常細胞分化階段的免疫標誌。國際上用“分化簇”(CD:clusterofdifferentiation)對單克隆抗體(McAb)統一命名。將ALL主要分為T細胞系和B細胞系兩大類。兒童ALL以B細胞係為主,占80%左右。B細胞系ALL又可分為若干亞類,目前尚無統一標準,各家不一,有的分為四型,有的分為六型。T細胞學ALL一般分為三型。
由於白血病細胞具有“異質性”和“非同步性”,其免疫表型的表達差異非常大。少數病人可以同時或先後表達兩種或兩種以上系列的特徵,稱為混合性白血病(mixedlineageleukemia,MAL)或雜合性白血病(hybridleukemia,HAL)。這類白血病可能起源於多能幹細胞。一般分為三型:
①雙表型,指同一個白血病細胞同時表達淋系和髓系特徵;
②雙系型(雙克隆型),指同時存在具有淋系和髓系特徵的兩群獨立細胞群;
③轉換型,指白血病細胞由一個系列向另一個系列轉化。
3、細胞遺傳學分型由於細胞遺傳學的發展,特別是高分辨分帶技術以及分子探針的套用,使白血病的分型又向前推進一步。目前發現90%以上的ALL具有克隆性染色體異常。
染色體異常包括數量異常和結構異常。ALL多數表現為46條染色體,其中以假二倍體為主,其次為超二倍體。
急性淋巴細胞白血病(1)數量異常
①超二倍體,約占ALL的1/4,以前B-ALL多見。雖然二倍體可累及任何一條染色體,但以4、6、10、14、17、18、20、21及X染色體最常見。
②假二倍體,即伴有結構異常的46條染色體,常表現為染色體易位。以L2型多見。
③亞二倍體,較少見,約占3%~8%,以45條者居多,一般為20號染色體缺失。
(2)結構異常兒童ALL中,已發現近40種非隨機的染色體結構異常,其中約50%為染色體易位,多數已明確其基因定位。
4、MIC分型1985年4月在比利時組成了MIC協作組,將形態學、免疫學和細胞遺傳學結合起來,制定了MIC分型。
5、臨床分型臨床一般將ALL分為標危(standardrisk,SR)和高危(highrisk,HR)兩大類。根據1993年4月廣西北海會議制定的評分標準,凡總積分<3分者為標危型,≥3分者為高危型。
臨床表現
各型ALL的臨床表現雖有一定差異,但基本是相同的。分述如下:
臨床表現 上呼吸道感染1、一般症狀除T-ALL起病較急外,一般起病相對緩慢。早期多表現為倦怠、無力或煩躁、食欲不振、偶有嘔吐。亦有最初表現為病毒性上呼吸道感染的症狀,或出現皮疹,然後出現無力等症狀。骨、關節疼也是較常見症狀。
2、貧血早期即出現進行性蒼白,以皮膚和口唇黏膜較明顯,隨著貧血的加重可出現活動後氣促,虛弱無力等症狀。T-ALL由於發病較急,確診時貧血反而不嚴重。
3、發熱半數以上有發熱、熱型不定。發熱的原因主要是繼發感染。
4、出血約半數病人有鼻衄、牙齦出血和皮膚紫癜或瘀點、瘀斑,偶見顱內出血。出血原因除血小板的質與量異常外,亦可由於白血病細胞對血管壁的浸潤性損害,使滲透性增加。T-ALL偶可發生DIC,可能由於原始T-ALL細胞釋放凝血酶、激酶等物質所致。
5、白血病細胞在臟器浸潤所致的症狀約2/3患兒有脾臟輕或中度腫大,肝臟多輕度腫大,質軟。淋巴結腫大多較輕,局限於頸、頜下、腋下、腹股溝等處。有腹腔淋巴結浸潤者常訴腹痛。約有1/4的患兒以骨或關節痛為起病的主要症狀。這是由於白血病細胞浸潤骨膜或骨膜下出血所致。
顱內壓增高症狀可出現在病程的任何時期,尤其在套用化療而未採取有效的中樞神經系統白血病預防者。T-ALL在發病早期即出現中樞神經系統浸潤,此類患兒多合併縱隔淋巴結腫大或胸腺浸潤,而產生呼吸困難、咳嗽等症狀。
睪丸浸潤可致睪丸無痛性腫大。隨著病程的延長,若不採用有效預防措施,睪丸白血病的發生將增多。合併睪丸白血病的平均病程為13個月,大多在骨髓處於完全緩解時發生。若不及時治療,則可導致骨髓復發。
浸潤表現
(1)骨和關節疼痛骨和骨膜的白血病浸潤引起骨痛(兒童比成人、ALL比AML多見),可為肢體或背部的瀰漫性疼痛,亦可局限於關節痛,常導致行動困難,並易誤診為骨髓炎或風濕病。愈1/3患者有胸骨壓痛,此征有助於本病診斷。有少數骨劇痛是由骨髓壞死引起。(2)肝脾和淋巴結腫大以輕、中度肝脾腫大為多見,一般不超過肋下4至6cm。ALL比AML肝脾腫大的發生率較高,腫大程度也更明顯。淋巴結腫大ALL也比AML多見,可累及淺表或深部如縱隔、腸系膜、腹膜後等淋巴結,但腫大程度一般較輕,直徑通常≤3.0cm。肝脾淋巴結腫大般在T-ALL、B-ALL更為明顯。
(3)中樞神經系統白血病(CNSL)CNSL常出現在ALL緩解期,初診患者相對少見。浸潤部位多發生在蛛網膜、硬腦膜,其次為腦實質、脈絡膜或顱神經。重症者有頭痛、嘔吐、項強、視乳頭水腫,甚至抽搐、昏迷等顱內壓增高的典型表現。類似顱內出血;輕者僅訴輕微頭痛、頭暈。顱神經(第VI、VII對顱神經為主)受累可出現視力障礙和面癱等。
(4)其他組織和器官浸潤ALL皮膚浸潤比AML少見,但睪丸浸潤較多見,睪丸白血病也常出現在緩解期ALL,表現為單或雙側睪丸的無痛性腫大,質地堅持硬無觸痛,是僅次於CNSL的白血病髓外復髮根源。白血病浸潤還可累及肺、胸膜、腎、消化道、心、腦、子宮、卵巢、乳房、腮腺和眼部等各種組織和器官,並表現相應臟器的功能障礙,但也可無症狀表現。
輔助檢查
急性淋巴細胞白血病 骨髓象1、血象白細胞的改變是本病的特點。白細胞總數可高於100×109/L,亦可低於1×109/L。約30%在5×109/L以下。未成熟淋巴細胞在分類中的比例可因診斷早晚和分型而不同。多數超過20%,亦有高達90%以上者。少數病人在早期不存在未成熟淋巴細胞,此類白血病分類中以淋巴細胞為主。
貧血一般為正細胞正色素性。但嚴重者,其MCV可能增高,可能由於骨髓紅細胞生成障礙所致。網織紅細胞正常或低下。貧血程度輕重不一,發病急者,貧血程度較輕。血小板大多減少,約25%在正常範圍。
2、骨髓象骨髓檢查是確立診斷和評定療效的重要依據。骨髓增生活躍或極度活躍,少數可表現增生低下。分類以原始和幼稚淋巴細胞為主,多超過50%以上,甚至高達90%以上。有的骨髓幾乎全部被白血病細胞所占據,紅系和巨核細胞不易見到。
急性淋巴細胞白血病骨髓象3、組織化學染色主要用於研究骨髓細胞的生物化學性質,有助於鑑別不同類型的白血病。ALL的組織化學特徵為
①過氧化酶染色和蘇丹黑染色陰性;
②糖原染色(±)~(■);
③酸性磷酸酶(-)~(±),T細胞胞漿呈塊狀或顆粒狀,其它亞型為陰性;
④非特異性脂酶陰性,加氟化鈉不抑制。
4、其他檢查出血時間延長可能由於血小板質與量異常所致。白血病細胞浸潤可造成凝血酶原和纖維蛋白原減少,從而導致凝血酶原時間延長和出血。肝功能檢查SGOT輕度或中度升高。由於骨髓白血病細胞大量破壞,致使LDH增高。
胸部X線檢查有5%~15%的患兒可見縱隔腫物,為胸腺浸潤或縱隔淋巴結腫大。長骨片約50%可見廣泛骨質稀疏,骨幹骺端近側可見密度減低的橫線或橫帶,即“白血病線”。有時可見骨質缺損及骨膜增生等改變。
診斷及鑑別診斷
典型病例根據病史、血象和骨髓象診斷並不困難。但有些病例在發病早期外周血白細胞數正常或減少,且可不出現幼稚細胞,常常被誤診。因此遇到一些可疑的病例,如不明原因的發熱、貧血、出血、骨關節痛、肝脾淋巴結腫大等應早期提高警惕,考慮到白血病,及時做骨髓穿刺檢查以明確診斷。骨髓檢查對於診斷十分重要,但應注
鑑別診斷急性淋巴細胞白血病對於不典型病例應與下列疾病鑑別:
1、再生障性貧血出血、貧血、發熱和全血減少與白細胞減少的ALL相似。但肝、脾和淋巴結不腫大,骨髓中無幼稚細胞增多。
2、惡性腫瘤骨轉移如神經母細胞瘤,可出現全血減少,並可有突眼,外周血出現特殊細胞。但骨髓檢查,瘤細胞多成堆或呈菊團狀排列,尿VMA增高,且多可找到原發瘤。
3、風濕與類風濕關節炎發熱、關節痛、貧血、白細胞增高等與ALL類似,但肝、脾、淋巴結多不腫大,行骨髓檢查則不難區別。
4、傳染性單核細胞增多症肝脾、淋巴結腫大,白細胞增多並出現異型淋巴細胞,有時易與ALL混淆。但多無血小板減少,骨髓檢查無原幼淋巴細胞增多,嗜異凝集反應陽性。
5、傳染性淋巴細胞增多症雖有白細胞總數增多,淋巴細胞增高。但皆為成熟的小淋巴細胞,且無貧血和血小板減少,骨髓檢查不難鑑別。
治療
20年來,由於新的抗白血病藥物不斷出現,新的化療方案和治療方法不斷改進,ALL的預後明顯改善。現代的治療已不是單純獲得緩解,而是爭取長期存活,最終達到治癒,並高質量生活。
化療長春新鹼聯合化療是白血病治療的核心,並貫徹治療的始終。其目的是儘量殺滅白血病細胞,清除體內的微量殘留白血病細胞,防止耐藥的形成,恢復骨髓造血功能,儘快達到完全緩解,儘量少損傷正常組織,減少治療晚期的後遺症。白血病的緩解標準是:
(1)完全緩解(CR)
①臨床無貧血、出血、感染及白血病細胞浸潤表現;
②血象血紅蛋白>90g/L,白細胞正常或減低,分類無幼稚細胞,血小板>100×109/L;
③骨髓象原始細胞加早幼階段細胞(或幼稚細胞)<5%,紅細胞系統及巨核細胞系統正常。
(2)部分緩解:臨床、血象及骨髓象3項中有1或2項未達到完全緩解標準,骨髓象中原始細胞加早幼細胞<20%。
(3)未緩解:臨床、血象及骨髓象三項均未達到完全緩解標準,骨髓象中原始細胞加早幼細胞>20%,其中包括無效者。
設計化療方案時,應考慮周期特異性與周期非特異性藥物聯合套用,選擇周期特異性藥物時,應選用不同時相的藥物配伍。
化療方案急淋的治療分為4部分:
①誘導治療;
②鞏固治療;
③庇護所預防;
④維持和加強治療。
正確的診斷、分型是選擇治療方案的基礎。應當根據每個病人的具體情況設計方案,即“個體化”。
化療潑尼松(1)誘導緩解治療急性白血病初診時,體內有1012以上的白血病細胞。本期的目的是在短期內迅速大量殺滅白血病細胞,恢復骨髓正常造血功能和臟器功能。兒童ALL的誘導緩解比較容易,簡單的VP方案(VCR+Pred)即可使CR率達到95%左右。但套用較弱的方案時,體內殘存的白血病細胞較多,且容易形成多藥耐藥,因而易於復發。許多研究證實,白血病的治療關鍵在於早期階段。因此主張在治療早期採用強烈、大劑量、聯合方案,在短期內達到CR,最大程度地殺滅白血病細胞,減少微量殘留白血病細胞數量,防止耐藥形成。
A、標危ALL:目前常用的方案有
①VCLP:VCR每次1.5~2mg/m2,靜注,每周一次,共4次;CTX600~800mg/m2,於治療第一天靜注;Pred40~60mg/(m2·d),口服,共4周;L-Asp10,000u/m2,靜脈或肌肉注射,於治療第二或三周開始,共6~10次。
②VDLP:即CTX換為DNR每次30~40mg/m2,靜注,連用2日。其它同上。
③CODLP(或COALP):即在VCP基礎上加DNR每次30~40mg/m2,連用2日。
套用上述方案,95%以上的病人於治療2~4周可獲CR。由於開始即套用3~4種藥物,白細胞降低明顯,容易合併感染。L-Asp無骨髓抑制的作用,故主張於治療的第3周開始套用,效果較好。
B、高危ALL:儘可能採用強烈化療,否則即使達到CR,骨髓、中樞神經系統和睪丸白血病的復發率仍很高。因此必須採用4~6種大劑量的化療藥物,如大劑量CTX,Ara-C,DNR、MTX,VM26或VP16、IDR等。常用的方案有:
①COAP:CTX400mg/m2於治療第1、15天靜注;VCR1.5~2mg/m2,每周一次,Ara-c100mg/m2,每12小時一次,肌注或靜注,連用5~7天第1,3周用;Pred60mg/(m2·d),口服,連用4周。
②CODLP:CTX800~1000mg/m2,於治療第一天靜注;DNR每次30~40mg/m2,於第2,3天靜注各一次;VCR,Pred用
化療甲氨蝶呤法同上;第3周加用L-ASP,連用10天,10,000U/(m2·d)。
用以上方案,一般於第二周末(一個療程)即可達到CR。如獲得部分緩解,可用原方案再進行一個療程。若治療五天血象無明顯好轉,或4周后骨髓未達到CR,則應改換其他方案,如VM26+Ara-c或IDR+Ara-c等。
(2)鞏固治療經誘導緩解達到CR後,用原誘導方案繼續治療2個療程。套用CODP或PODP等強烈方案者,可給予L-ASP10,000U/(m2·d),靜注或肌注,連用10天。或更換其他方案交替使用。
(3)庇護所預防由於血腦屏障的存在,一般劑量的化療藥物很難通過腦膜,達不到有效的藥物濃度,因而不能有效殺滅中樞神經系統內的白血病細胞,故容易發生中樞神經系統白血病(CNSL)。同樣,由於血睪屏障的存在,加之睪丸組織的溫度低,代謝緩慢,睪丸內的白血病細胞容易形成耐藥,導致睪丸白血病。隨著白血病生存期的延長,CNSL和睪丸白血病的發病數逐漸增高。若不進行庇護所預防,約50%的ALL患兒在CR三年內可發生CNSL;約10%~15%的男孩發生睪丸白血病,成為白血病復發的重要原因,因此庇護所的預防是白血病治療的重要環節。
中樞神經系統白血病的預防:初診時白細胞>25×109/L,血小板低者,B-ALL及T-ALL容易發生CNSL。高危組的發生率明顯高於標危組,且發生時間早。採用強烈化療者,採用大劑量MTX,Ara-C及L-ASP者CNSL發生率較低。
由於部分病例初診時已出現中樞神經系統的侵犯,因此CNSL的預防應從治療開始時即進行。常用的預防方法有:
①單純藥物鞘註:一般採用MTX、AraC、DXM三聯鞘注,按兒童腦室容量計算給藥。於治療第一天鞘注一次。待CR後每周鞘注一次,連續四次,以後每8周一次,直至停藥。
急性淋巴細胞白血病放療②顱腦放療加鞘註:即CR後用直線加速器或60Co照射,每周5次,連續3周,標危及高危病人總量分別為1800cGy及2000cGy。鞘注於第一天注射一次。放療期間每周一次,共4次。放療後每3個月一次。緩解2年後改為每4個月一次。劑量同前。
③大劑量MTX、放療及鞘注並用大劑量MTX靜注既能預防CNSL,又能預防睪丸白血病,是套用最廣泛的方法。中劑量MTX(每次500~1000mg/m2)效果不佳,目前多不採用。在鞏固治療完成後套用大劑量MTX每次3g/m2,靜注,共三個療程,間隔10~14天。1/10量靜脈推注,其餘9/10量在6小時內均勻靜脈滴注。為預防大劑量MTX的毒性反應,應給予水化、鹼化。入量3000ml/(m2·d),其中包括5%碳酸氫鈉80~100ml/(m2·d)。一般在注射前3小時先輸入含碳酸氫鈉的液體,鹼化尿液,使尿pH>7.0,比重<1.010。用藥開始36小時後開始四氫葉酸鈣解救,每次15mg/m2,第1次肌注,以後每6小時給藥一次,即42、48、54、60、66小時各給藥一次,靜脈、肌注或口服。於靜注MTX2小時後鞘注一次,此後每8周鞘注一次,直至大劑量MTX後6個月進行顱腦放療。套用大劑量MTX同時用VP方案。
由於顱腦放療影響兒童的神經系統發育、智力、生長及性腺發育。因此對於標危病人多數人不再主張用此方法作為預防CNSL的手段。睪丸白血病的預防睪丸白血病多發生於高危病人。作為預防措施必須在緩解後套用大劑量MTX,用法如前述。
(4)維持治療與加強治療經誘導緩解後,體內約有108~1010的微量殘留白血病細胞。如此時停藥,則很快復發,故需要繼續維持治療,最大程度殺滅並最終清除MRLC。為防止產生耐藥性,需採用幾種藥物交替輪換使用。但由於維持治療需要較長時間,強烈的化療會導致嚴重骨髓抑制、免疫功能低下和臟器損害(如肝功能損害),因此不應使用蓄積毒性較大的藥物。為了加強對MRLC的殺死,需要間歇重複原誘導方案,即“再誘導”或“小加強”,並定期給予衝擊性治療,即“強化”治療。
目前維持治療的方案有多種,最簡單而有效的方法是6MP十MTX,MTX每周20mg/m2,靜脈或口服;MP50~75mg/(m2.d),口服,連用2周,再用原誘導方案或COAP強化一周。每月用藥3周,休息一周。
加強治療的方法差異較大,目前多用Ara-C+VM26,即VM26每次150mg/m2,Ara-C每次300mg/m2,共用2次,間隔2天。加強治療的間隔時間一般在1年內每3個月1次,以後逐漸延長。由於L-ASP對於清除MDR效果較好,故在維持階段可定期使用。
維持治療應持續多長時間,目前尚無統一標準,主要根據化療方案的設計而定。一般為2年半~3年半。高危病人持續時間可適當延長。有報告3年停藥與3年以上停藥的復發率幾無差異。
復發的治療
1、骨髓復發:骨髓復發的預後與復發的時間有關。持續完全緩解(Continuedcompleteremission,CCR)3年以上者;尤其停藥後復發者預後較好,約80%以上的病人可以獲得第二次緩解,約40%的病人可以長期存活。若在治療18個月以內復發,則預後不良。由於對多種藥物已經產生耐藥(multipledrugresistance,MDR),獲得第二次緩解的機會較少。既使獲得緩解,大部分病人很快復發。
化療柔紅黴素骨髓復發必須採用更為強烈的再誘導方案,套用二線化療藥物。如美國CCSG協作組對第一次復發的病人套用VDLP方案,其中DNR每周25mg/m2,共用4次;L-ASP10000u/m2,每周3次,共12次,可使82%的病人獲得第二次緩解。VM26與Ara-C並用亦可使再次緩解率達到87%。
由於骨髓復發後,再次進行化療獲得長期緩解的機會較少,故有條件的應做骨髓移植。
2、中樞神經系統復發:半數以上的CNSL病人無明顯症狀,故多被忽視,常在常規鞘注預防CNSL時方被發現。症狀多為頭痛、嘔吐、乏力,亦可出現面癱、視力減退、腦膜刺激征,嚴重的可發生偏癱、失語、抽搐和昏迷。
一般來說,CNSL發生在緩解一年以內者,其長期生存率明顯低於晚期復發者。近年來由於庇護預防的改進,CNSL的發生率已明顯減低。
CNSL的診斷標準為:
①有中樞神經系統症狀和體徵(尤其是顱內壓增高的症狀和體徵)。
②腦脊液的改變:壓力增高,>0.02kPa(200mmH2O),或>60滴/分;白細胞數>0.01×109/L;塗片見到白血病細胞;蛋白>450mg/L,或潘氏試驗陽性。
③排除其他原因所致中樞神經系統或腦脊液的相似改變。
CNSL的治療方法尚不統一,一般的方法包括:
①聯合鞘註:即MTX、Ara-C、DXM三聯鞘注,劑量同預防。第一周每2天鞘注1次,第二周每周2次,直至CSF正常兩次後,改為每1、2、3、6周各1次,此後每6~8周1次,直至停止化療。或開始每2天鞘注一次,直至CSF正常後改為每4~6周1次。
②放療:對反覆發生CNSL者,經鞘注CSF正常後進行顱腦放療18~26Gy,3周內完成,第4周開始脊髓放療10~18Gy。
③腦室內化療:利用Ommaya貯存器植入顱內,直接將藥物注入側腦室,使藥物均勻分布於整個蛛網膜下腔,並可減少反覆腰椎穿刺。但有一定危險性,導管位置不易固定,有合併感染的危險等。
③單純睪丸復發睪丸復發多在緩解2年以後,停藥後復發者比較多見。因此不能放鬆對睪丸的檢查。臨床多無自覺症狀,僅出現硬腫。開始多為一側腫大,若不進行治療,對側也可波及。睪丸白血病的治療主要為睪丸放療。一側睪丸復發時,應進行對側睪丸活檢。若僅為一側發生浸潤,則對患側進行放療。由於睪丸活檢往往不能反映整個睪丸的情況,因此主張對兩側睪丸同時放療,總量20~24Gy。若發現臨近部位及附近的淋巴結有白血病細胞浸潤,則放療亦應包括這些部位。
凡CNSL或睪丸白血病復發者,無論有無骨髓復發皆應進行全身再次誘導緩解治療,否則容易導致骨髓復發。
骨髓移植
骨髓移植(bonemarrowtransplantation,BMT)治療白血病是通過植入多能幹細胞,使白血病患兒因強烈化療和放療而受到嚴重損害的骨髓功能得到恢復,並通過移植引起的移植物抗白血病作用(graftversusleukemia,GVL)消滅化療和放療後微量殘留白血病細胞(minimalresidualleukemiccell,MRLC)。由於BMT技術和方法不斷改進,移植成功率亦隨之提高,為白血病的治療開闢了一條新的途徑。由於聯合化療對兒童ALL效果較好,故先不採用BMT治療。但對於部分高危、復發和難治的病例,BMT往往是最有效的治療手段。
預後
自然病程較短,若不治療,一般多在6個月內死亡,平均病程約3個月。自從套用聯合化療以來,預後有了明顯改善。緩解率可達95%以上,目前已開發國家如德國BFM協作組的五年無病生存率已達到80%,國內的五年無病存活率也達到74%以上。因此ALL已成為一種可治癒的惡性腫瘤。
一般認為高危患兒較標危患兒預後差。此外,化療後達到完全緩解的時間與預後關係密切。誘導治療後,周圍血幼稚細胞在5天內減少一半,骨髓於2周內明顯好轉,4周內達到完全緩解者,則預後較好。
併發症
1.發熱發熱是急性白血病的最常見的併發症,約半數以上患者以發熱起病,當體溫>38.5℃時常常是由感染引起的,其熱型不一且熱度不等,發熱的主要原因是細菌或病毒感染;極少數患者還可發生局灶性或多部位壞死,引起高熱或骨骼疼痛。2.出血急性白血病的整個病程中,幾乎所有的患者都會有不同程度的出血,40%~70%患者起病時就有出血,有研究報導,成人ALL患者血小板在10×109/L和20×109/L的死亡率無明顯差異,只有當血小板<5×109/L時,才可能發生致命性出血,嚴重的感染尤其是革蘭氏陰性桿菌感染易誘發DIC。
3.白血病髓外併發症由於白血病細胞可以侵犯各種組織器官,或影響各系統功能,因此可引起多種併發症,有時這些系統的併發症甚至成為患者的主要臨床表現,報導中的多數系統併發症與白血病細胞有直接的關係,有些則沿不能明確其發病機制。
(1)呼吸系統併發症:成人呼吸窘迫綜合徵;結節病;胸腔積液;肺纖維化。
(2)循環系統併發症:心包積液,某些ALL的首發表現為心包積液,對難治性ALL或復發ALL而言,心包積液並非少見表現,心律失常;心功能衰竭;高血壓等。
(3)消化系統併發症:急腹症;門脈高壓;消化道出血。
(4)泌尿系統併發症:腎浸潤,兒童ALL可能更易發性腎浸潤;腎功能不全;睪丸白血病;可發生任何年齡的ALL,以兒童ALL最常見,8歲以下ALL占全部TL的86.6%,CLL與CML偶爾發生TL,高危ALL更易發生,TL初診時白血胞>30×109/L是TL的危險因素。
(5)血液系統併發症:血小板減少症與DIC;血栓的形成;溶血性貧血;骨髓壞死;高白細胞狀態與白細胞淤滯綜合徵:一般而言,AL患者外周血白細胞計數大於100×109/L或慢性外周血白細胞計數大於500×109/L稱為高白細胞狀態,由此引起的各種白細胞淤滯的表現稱為高白細胞淤滯綜合徵,占15%~20%,較易發生高白細胞狀態的AL類型有ALL,AML-M5,AML-M1等。
(6)內分泌與代謝併發症:糖尿病,尿崩症,病態甲狀腺綜合徵,電解質紊亂,白血病發生TLS時,常表現為高鉀血症,高磷血症及低鈣血症,白血病並發的電解質紊亂亦可表現為低鉀血症,高鈣血症,低鉀血症不及高鉀血症常見,生長發育異常,兒童白血病長期接受化療可致生長發育異常,卵巢白血病,白血病細胞浸潤卵巢並不多見,主要見於ALL。
(7)神經系統併發症:顱內出血,是白血病嚴重患者併發症,是導致患者死亡的主要原因之一,引起顱內出血的原因有:血小板明顯減少,白血病細胞浸潤腦血管,DIC,體內抗凝物增加等,中樞神經系統白血病是ALL最常見的併發症,癲癇:白血病患者並發癲癇發作的原因可能有CNSL,顱內出血,顱內感染或全身嚴重感染,藥物的副作用,部分患者未能明確原因,另外,白血病患者還可並發麵神經麻痹,動眼神經麻痹,腓總神經系麻痹,腦膜炎,急性腦-脊髓炎,小腦綜合徵,感染中毒性腦病,腦炎等,多與白血病細胞浸潤,壓迫,感染,藥物毒性等因素有關。
4.其他併發症如皮膚損害,骨關節病變,視網膜出血,水腫,耳聾,急性腮腺炎等。